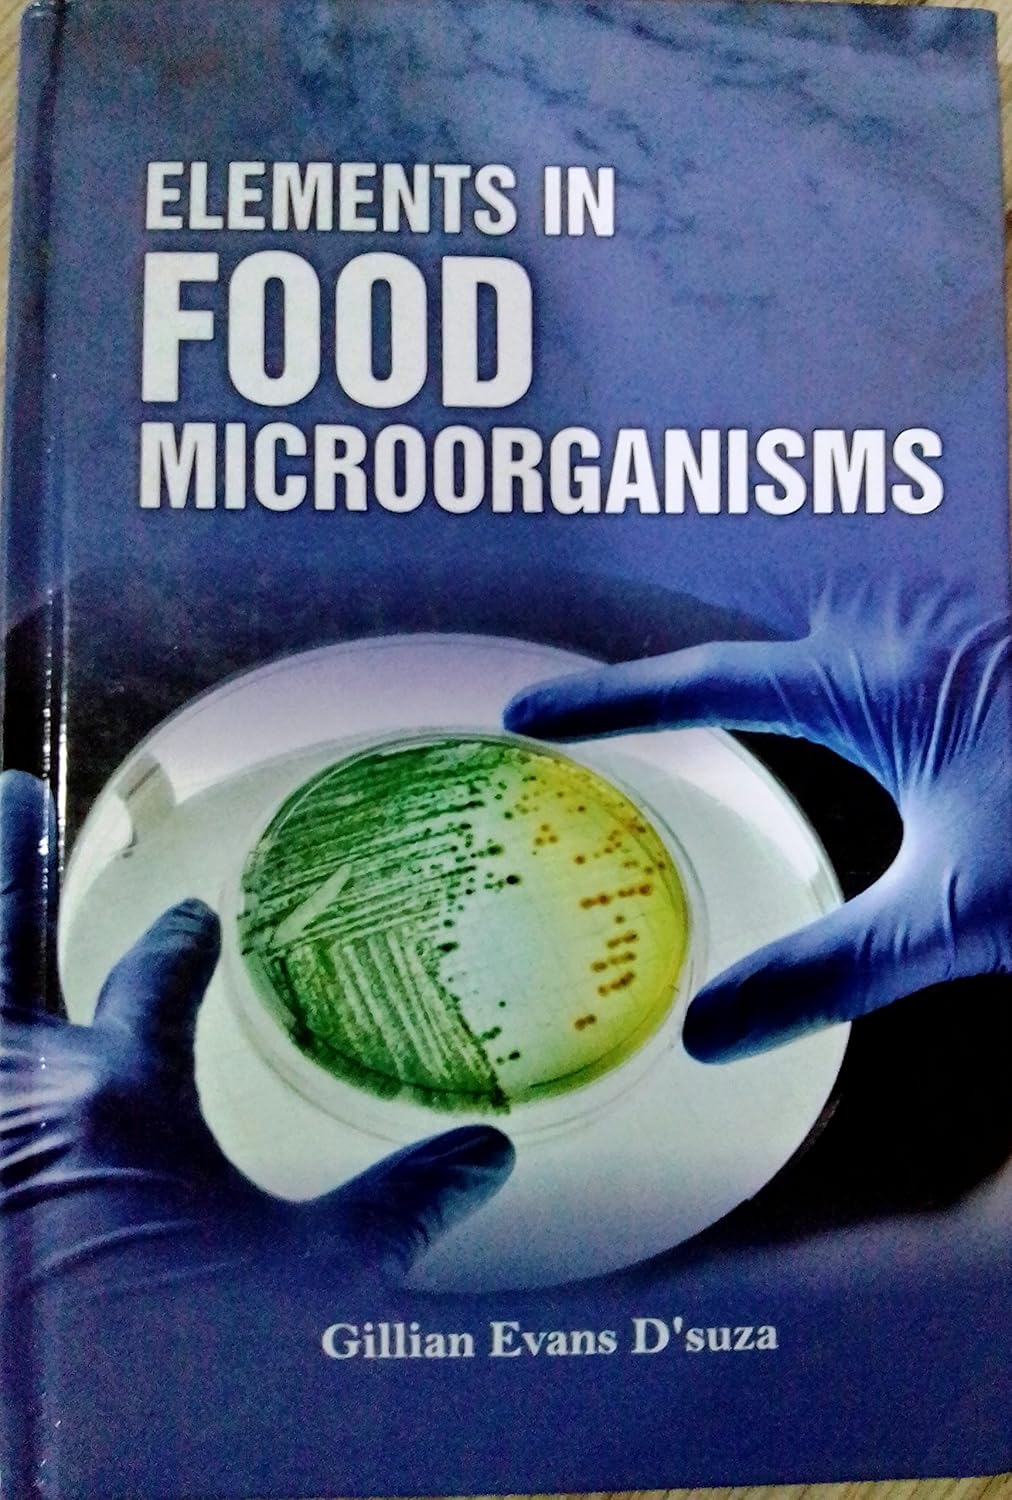
Elements in Food Microorganisms

Elements in Food Microorganisms
Elements in Food Microorganisms
Couldn't load pickup availability
Microorganisms are widely used in the food industry to produce various types of foods that are both nutritious and preserved from spoilage because of their acid content. In the dairy industry, many products result from fermentation by microorganisms in milk and the products of milk. Several microbially-produced polymers are used in the food industry. Other fermented foods are also the product of microbial action. Currently, more than 3500 traditionally fermented foods exist in the world. They are of animal or vegetable origin and are part of our daily life. Alcoholic drinks are not the only fermented drinks; cocoa beans, coffee grains and tea leaves are fermented after harvest in order to develop their typical flavour profiles. This book contains an useful first-hand information of food microorganisms for the people who are working in food processing industries. The students of microbiology, food science and technology, biotechnology, biochemistry, home science, food and nutrition, veterinary science, hotel and catering management and other food-related courses will find it as a valueable resource in their study.
Share